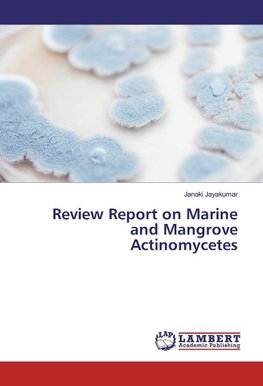
Review Report on Marine and Mangrove Actinomycetes

-
 Anglický jazyk
Anglický jazyk
Review Report on Marine and Mangrove Actinomycetes
Autor: Janaki Jayakumar
Actinomycetes growing in high saline environments represent an important source of biologically active compounds. Many antibacterial, antifungal, anti-tumour, cytotoxic and photo protective compounds have been isolated from these areas. Marine and mangrove... Viac o knihe
Na objednávku
33.30 €
bežná cena: 37.00 €
O knihe
Actinomycetes growing in high saline environments represent an important source of biologically active compounds. Many antibacterial, antifungal, anti-tumour, cytotoxic and photo protective compounds have been isolated from these areas. Marine and mangrove actinomycetes can be a source of drugs with novel chemistry and promising potential. Since marine and mangrove areas are closely related to each other, here I consolidated the research work done by the other researchers related to this area only. The present work consolidated the reports available on diversity, antagonistic activity, physiological and biochemical characterization, 16sRNA sequencing and phylogenetic analysis, bioactive compounds, anticancer activity, antioxidant activity, mosquito larvicidal activity, keratinase activity and heavy metal accumulation and degradation. I assure you that this review report could help new dimension to your mangrove and marine actinomycetes study also. I thank all the researchers those who did wonderful work with this emerging field for better drug delivary from marine and mangrove actinomycetes and also for their contribution to our society.
- Vydavateľstvo: LAP LAMBERT Academic Publishing
- Rok vydania: 2016
- Formát: Paperback
- Rozmer: 220 x 150 mm
- Jazyk: Anglický jazyk
- ISBN: 9783659933486












